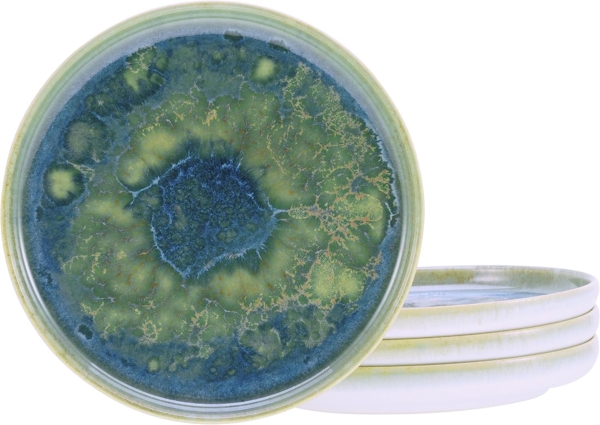
CreaTable, 21510, Serie Yuki, Brotteller 4 teilig

Diese Cookies und andere Informationen sind für die Funktion unserer Services unbedingt erforderlich. Sie garantieren, dass unser Service sicher und so wie von Ihnen gewünscht funktioniert. Daher kann man sie nicht deaktivieren.
Zur Cookierichtlinie
Unvergleichlich lecker
Mit dem Klick auf „geht klar” ermöglichen Sie uns Ihnen über Cookies ein verbessertes Nutzungserlebnis zu servieren und dieses kontinuierlich zu verbessern. So können wir Ihnen bei unseren Partnern personalisierte Werbung und passende Angebote anzeigen. Über „anpassen” können Sie Ihre persönlichen Präferenzen festlegen. Dies ist auch nachträglich jederzeit möglich. Mit dem Klick auf „Nur notwendige Cookies” werden lediglich technisch notwendige Cookies gespeichert.
Ihre Cookie-Präferenzen verwalten
Wählen Sie, welche Cookies Sie auf check24.de akzeptieren.
Die Cookierichtlinie finden Sie hier.
Die Cookierichtlinie finden Sie hier.
Notwendig
Analytisch
Wir möchten für Sie unseren Service so gut wie möglich machen. Daher verbessern wir unsere Services und Ihr Nutzungserlebnis stetig. Um dies zu tun, möchten wir die Nutzung des Services analysieren und in statistischer Form auswerten.
Zur Cookierichtlinie
Zur Cookierichtlinie
Marketing
Um Ihnen unser Angebot kostenfrei anbieten zu können, finanzieren wir uns u.a. durch Werbeeinblendungen und richten werbliche und nicht-werbliche Inhalte auf Ihre Interessen aus.
Dafür arbeiten wir mit ausgewählten Partnern zusammen. Ihre Einstellungen können Sie jederzeit mit Klick auf Datenschutz im unteren Bereich unserer Webseite anpassen.
Ausführlichere Informationen zu den folgenden ausgeführten Verarbeitungszwecken finden Sie ebenfalls in unserer Datenschutzerklärung.
Zur Cookierichtlinie
Zur Cookierichtlinie
Zum Hauptinhalt
Profil
Konto
Services
Gutscheine und Punkte
Entdecken
Optimierungscenter
Profil
Konto
Services
Gutscheine und Punkte
Entdecken
Optimierungscenter
CreaTable, 21510, Serie Yuki, Brotteller 4 teilig
von Creatable
8 Bewertungen
Preisentwicklung
4 Angebote
-12%
▼
Lieferung Di. 13.01. - Fr. 16.01.
Kostenlose Retoure, 30 Tage


Rechnung
Sofortüberweisung
Lastschrift
10Punkte
37,62 €3762€Versandkostenfrei
38,70 €
- 1,08 € Rabatt
jetzt kaufen
in den Warenkorb
Nur noch 19 verfügbar
Partnerbewertung
5,0/5
Lieferzeit
Einhaltung der angebenen Lieferzeit
100,0%
Warenverfügbarkeit
Einhaltung der angegebenen Verfügbarkeit
99,4%
So funktionieren unsere Kundenbewertungen
Kundenbewertungen mit Kommentar
Noch keine Kundenbewertungen mit Kommentar vorhanden.
« vorherige
nächste »
119.370
Lieferung Mi. 14.01. - Fr. 16.01.
Kostenlose Retoure, 14 Tage
37,99 €3799€Versandkostenfrei
zum Shop
Partnerbewertung
4,4/5
Kundenbewertungen
Bei CHECK24, Google, eKomi und Trustpilot
119.370
So funktionieren unsere Kundenbewertungen
Kundenbewertungen mit Kommentar
Noch keine Kundenbewertungen mit Kommentar vorhanden.
« vorherige
nächste »
642
Lieferung Sa. 17.01. - Mi. 21.01.
Kostenpflichtige Retoure, 30 Tage


Rechnung
Sofortüberweisung
Lastschrift
10Punkte
39,77 €3977€Versandkostenfrei
jetzt kaufen
in den Warenkorb
Nur noch 19 verfügbar
Partnerbewertung
4,6/5
Kundenbewertungen
Bei CHECK24, Google, eKomi und Trustpilot
642
Lieferzeit
Einhaltung der angebenen Lieferzeit
98,3%
Warenverfügbarkeit
Einhaltung der angegebenen Verfügbarkeit
99,2%
So funktionieren unsere Kundenbewertungen
Kundenbewertungen mit Kommentar
Noch keine Kundenbewertungen mit Kommentar vorhanden.
« vorherige
nächste »
Lieferung Sa. 17.01. - Di. 20.01.
Kostenlose Retoure, 30 Tage
42,94 €4294€inkl. 4,95 € Versand
zum Shop
Partnerbewertung
null/5
So funktionieren unsere Kundenbewertungen
Kundenbewertungen mit Kommentar
Noch keine Kundenbewertungen mit Kommentar vorhanden.
« vorherige
nächste »